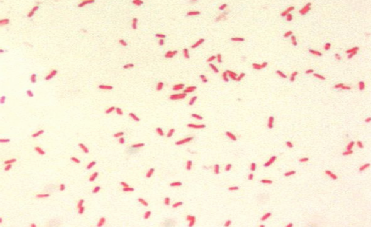
term image
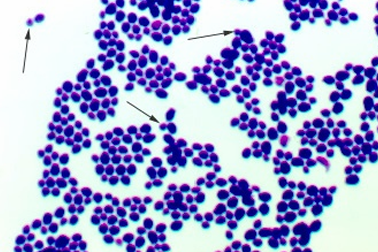
term image
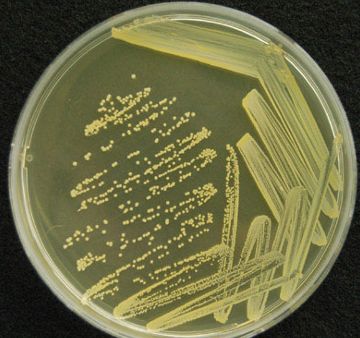
term image
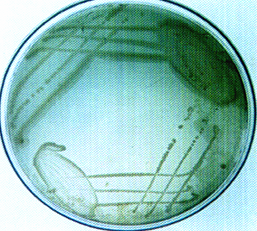
term image
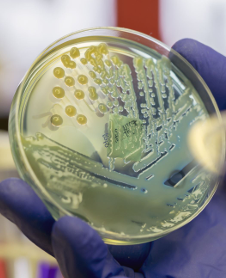
term image
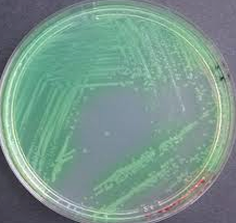
term image
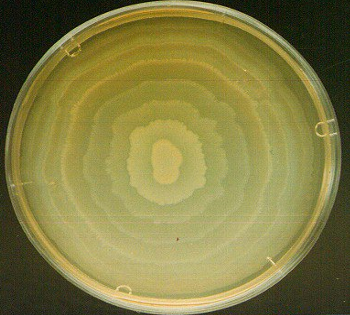
term image
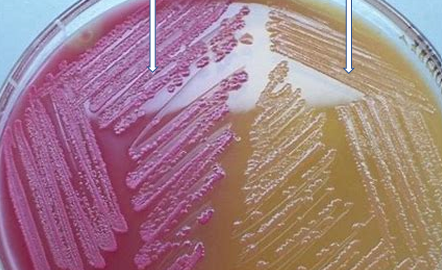
term image
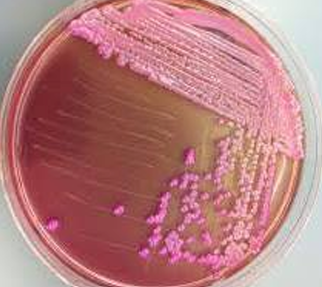
term image
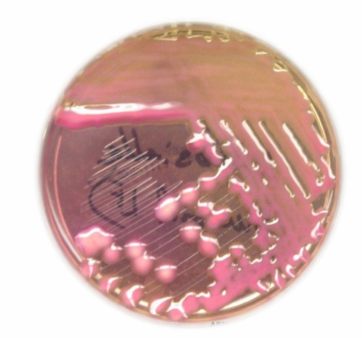
term image
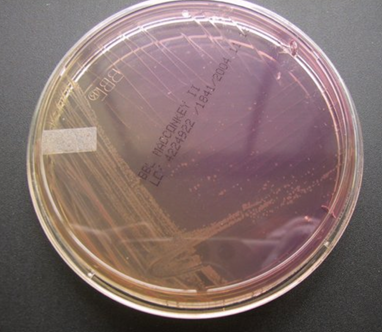
term image
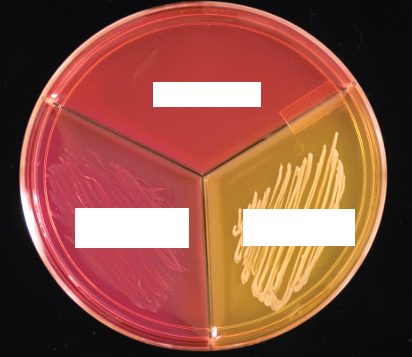
term image
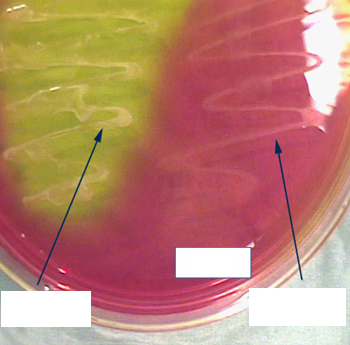
term image
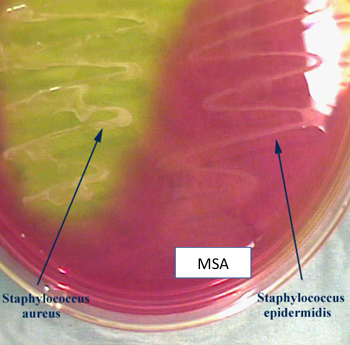
<p>Mannitol salt agar (MSA)</p>
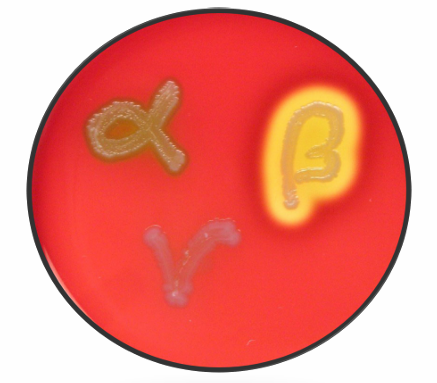
term image
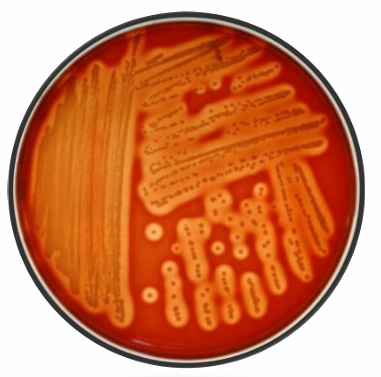
term image
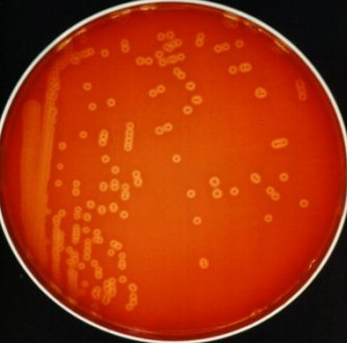
term image
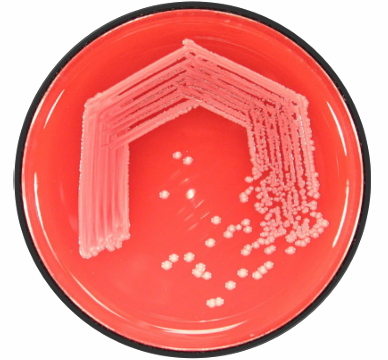
term image
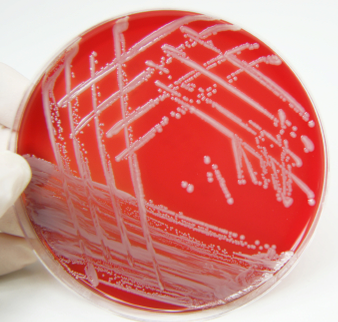
term image
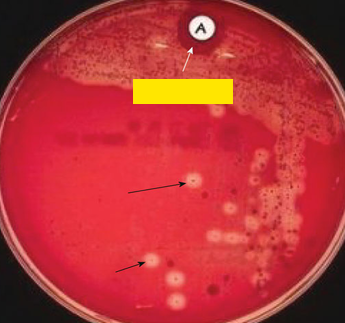
term image
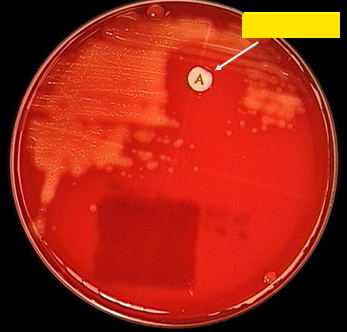
term image
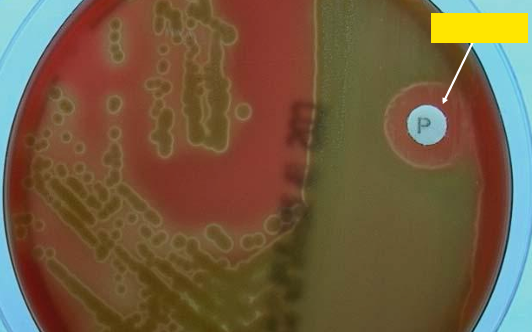
term image
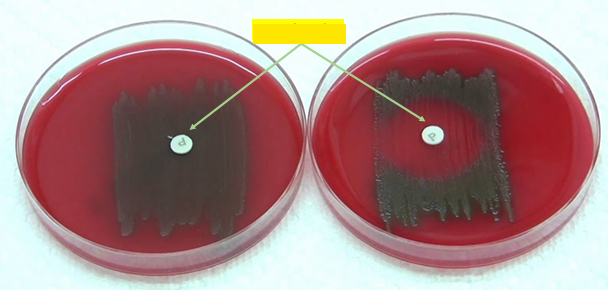
term image
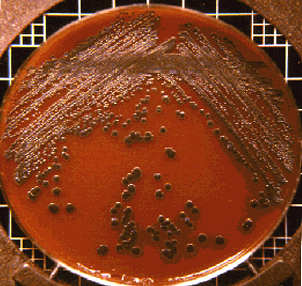
term image
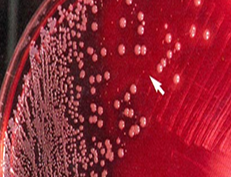
term image
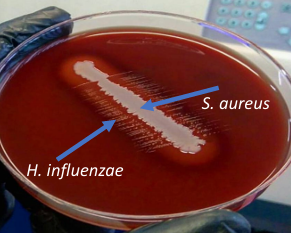
term image
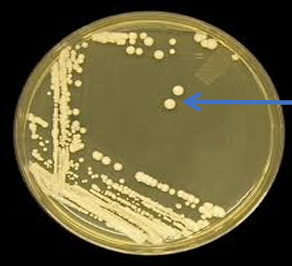
term image
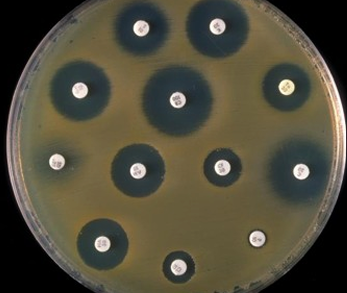
term image
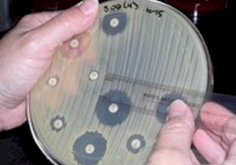
term image

Microbiology Resp Lab Flashcards, Yosyraa
1/74
There's no tags or description
Looks like no tags are added yet.
Name | Mastery | Learn | Test | Matching | Spaced | Call with Kai |
|---|
No analytics yet
Send a link to your students to track their progress
75 Terms

Streptococci in culture (Gram’s stain)

Streptococci in culture (Gram’s stain)

Streptococci in pus (Gram’s stain)

Streptococci in pus (Gram’s stain)

Pneumococci in tissue (Gram’s stain)

Pneumococci in pus (Gram’s stain)

Staphylococci in culture

Staphylococci in pus

Corynebacterium diphtheriae (Gram’s stain)

Corynebacterium diphtheriae (Methylene blue stain)

Vincent’s angina


Mycobacterium tuberculosis
(Acid fast bacilli) / (Z-N stain)

Mycobacterium tuberculosis
(Acid fast bacilli) / (Z-N stain)

Bacillus anthracis
(Gram’s stain)

Bacillus anthracis
(Gram’s stain)

Bacillus anthracis
(Spore stain)

Bacillus anthracis, McFaydean Reaction
(Polychrome methylene blue stain: blue bacilli surrounded by purple/pink capsule)

Gram negative bacilli
(Gram’s stain)
Gram negative bacilli
(Gram’s stain)

Klebsiella in tissue
(Gram’s stain)

Klebsiella in tissue
(Gram’s stain)
Candida
(Gram’s stain)

Germ Tube Test
(for differentiation of Candida albicans from other Candida spp.)
Candida albicans forms germ tubes in serum

Nutrient agar
Staphylococcus aureus on nutrient agar
(showing golden yellow endopigment)
Pseudomonas aeruginosa on Nutrient agar OR Pseudomonas exopigment on nutrient agar
Pseudomonas aeruginosa on Nutrient agar OR Pseudomonas exopigment on nutrient agar
Pseudomonas aeruginosa on Nutrient agar OR Pseudomonas exopigment on nutrient agar
Proteus on nutrient agar
(showing swarming growth)

MacConkey’s agar
MacConkey’s agar
Pink= Lactose Fermenter
Yellow= Non-lactose Fermenter
Lactose fermenter on MacConkey’s agar
Lactose fermenter on MacConkey’s agar
Lactose non-fermenter on MacConkey’s agar
Mannitol salt agar (MSA)

Mannitol salt agar (MSA)

Chocolate agar (for Haemophilus)

Blood agar
Types of haemolysis on blood agar
top left = alpha
top right = beta
lower = gamma

Alpha-haemolysis on blood agar
Beta-haemolysis on blood agar
Beta-haemolysis on blood agar
Non-haemolysis on blood agar
Non-haemolysis on blood agar
Bacitracin test (Bacitracin-sensitive organism: S. pyogenes)
Bacitracin test (Bacitracin-sensitive organism: S. pyogenes)
Optochin test
(Optochin-sensitive organism: Pneumococci)
Optochin sensitivity test
Optochin disc:
Optochin-resistant organism (viridans streptococci) (left)
Optochin-sensitive organism (pneumococci) (right)

Loffler’s serum for C. diphtheriae

Elek’s Test
Toxigenic C. diphtheriae

Elek’s Test
Non-Toxigenic C. diphtheriae
Corynebacterium diphtheriae on Blood Tellurite agar
Haemophilus influenzae on blood agar showing satellitism
(growth around Staphylococcus aureus culture)
Haemophilus influenzae on blood agar showing satellitism
(growth around Staphylococcus aureus culture)

Lowenstein Jensen (L.J.) medium
for M. tuberculosis

Lowenstein Jensen (L.J.) medium
for M. tuberculosis

Lowenstein Jensen (L.J.) medium
for M. tuberculosis

Mycobacterium Growth Indicator Tube (MGIT):
Positive fluorescence

Mycobacterium Growth Indicator Tube (MGIT):
Positive fluorescence (left arrow)
Negative florescence (right arrow)

Mycobacterium Growth Indicator Tube (MGIT):
Negative florescence

Sabouraud Dextrose agar (For Fungal culture)
Candida on Sabouraud’s dextrose agar (SDA)
colonies appear creamy white, pasty with yeasty odour
Antibiotic sensitivity test: Disc diffusion method
Antibiotic sensitivity test: Disc diffusion method

Antibiotic sensitivity test: Disc diffusion method

Biochemical reaction:
Catalase Test
Upper negative
Lower positive
organism:
staphylococci In catalase postive
streptococci in catalase negative

Biochemical reaction:
Catalase Test
left negative
right positive
organism: staphylococci

Biochemical reaction:
Coagulase Test
up coagulase positive - Staphylococcus aureus
up coagulase negative - Coagulase negative staphylococci, e.g., S. epidermidis

Biochemical reaction:
Oxidase Test
left oxidase negative
right oxidase positive
organism: pseudomonas

Biochemical reaction:
Oxidase Test
left oxidase positive
right oxidase negative
organism: pseudomonas

Biochemical reaction:
Oxidase Test
left oxidase negative
right oxidase positive
organism: pseudomonas

Biochemical reaction:
Indole Test
left Indole negative
right Indole positive

Biochemical reaction:
Citrate Test
left citrate positive
right citrate negative

Biochemical reaction:
Triple Sugar Iron (TSI)
left = TSI of carbohydrate fermenter
(e.g., E. coli, Klebsiella)
right = TSI of carbohydrate non-fermenter
(e.g., Pseudomonas aeruginosa)

Biochemical reaction:
Urease test
left = negative urea test
right = positive urea test
organism = proteus